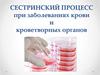
Сестринский процесс при заболеваниях крови и кроветворных органов

Similar presentations:
Сестринский уход при заболеваниях крови
1.
краевое государственное бюджетное профессиональноеобразовательное учреждение
«Владивостокский Базовый Медицинский Колледж»
Лекция
СЕСТРИНСКИЙ УХОД ПРИ
ЗАБОЛЕВАНИЯХ КРОВИ
Преподаватель: Сысоева Е.С.,
преподаватель первой квалификационной категории
Владивосток
2020
2.
Кровьявляется внутренней средой организма с
определенным морфологическим составом и
многообразными функциями.
Условно ее делят на две части: клетки
(эритроциты, лейкоциты и тромбоциты) и плазму,
в состав которой входят белки, углеводы, жиры,
ферменты, гормоны, витамины и другие
вещества.
Образование
клеток крови происходит в
кроветворных органах (красном костном мозге,
лимфатических узлах и селезенке).
По истечении срока жизни клетки крови
разрушаются
в
системе
мононуклеарных
фагоцитов.
3.
Схема кроветворения( по Воробьеву и Черткову)
4.
КровьОбщие сведения
Циркулирующая
Депонированная
(капиллярах селезенки,
лимфатических узлов, кожи)
Цельная кровь состоит из форменных элементов
(45 %) и жидкой части – плазмы (55 %).
Отношение объема форменных элементов к
объему плазмы носит название гематокрита.
5.
Эритроцитоз(от
лат.
erythrocytes
—
эритроцит,
греч. osis — патологическое увеличение) —
увеличение содержания эритроцитов в
единице объема крови.
Эритроцитоз
Первичный
Вторичный
Абсолютный
Относительный
6.
Первичный эритроцитоз— редкое, генетически обусловленное
заболевание, представляющее собой
самостоятельную нозологическую
единицу (болезнь Вакеза).
7.
Вторичный абсолютныйэритроцитоз
представляет собой один из симптомов, встречающийся
при различных патологических процессах.
Чаще всего вторичный эритроцитоз обусловлен
развившейся в организме гипоксией (сужение трахеи и
бронхов, пневмонии и гидроторакс, хронические
заболевания легких, недостаточная вентиляция
помещений, разреженный горный воздух; пороки
сердца, эмфизема легких).
Следствием гипоксии тканей является усиление
синтеза эритропоэтинов, которые активно стимулируют
эритроцитарный росток красного костного мозга, что
ведет к повышенному поступлению эритроцитов в
кровь.
8.
Вторичный относительныйэритроцитоз
выявляется
при
всех
состояниях,
вызванных
чрезмерной
потерей
жидкости.
Содержание эритроцитов и гемоглобина
в единице объема крови увеличивается
за счет снижения объема плазмы, что
наблюдается при усиленной мышечной
нагрузке, обильном отделении пота,
диареях
различной
этиологии,
гипертермии, лихорадке, полиурии.
9.
АНЕМИЯ- состояние, характеризующееся снижением
концентрации гемоглобина (менее 130 г/л у
мужчин и 120 г/л у женщин) и гематокрита
(менее 39% у мужчин и 36% у женщин),
обычно при этом также происходит и
снижение количества красных кровяных
телец (эритроцитов).
10.
Классификация анемии поэтиологии
первичная анемия
(обусловлена врожденными аномалиями
эритропоэза);
вторичная
(следствие неблагоприятных воздействий
на организм человека).
11.
Классификация анемии попатогенезу
· постгеморрагическая анемия
(следствие обильной кровопотери);
· гемолитическая (вызвана
преждевременным разрушением
эритроцитов).
· дизэритропоэтическая анемия
(связанная с нарушениями эритропоэза):
а. регенераторная;
б. арегенераторная;
в. апластическая.
12.
Классификация по цветовомупоказателю
· нормохромная (ЦП = 0,9-1,0);
· гипохромная (ЦП = 0,8 и ниже);
· гиперхромная (ЦП выше 1,0).
13.
Классификация анемий повеличине СДЭ
· микроцитарные – СДЭ ниже нормы
(железодефицитные и хроническая
постгеморрагическая анемии),
· нормоцитарные – СДЭ в пределах нормы
(острая постгеморрагическая и большинство
гемолитических анемий);
· макроцитарные – СДЭ выше нормы
(гемолитическая болезнь новорожденных, В12дефицитные, фолиеводефицитные анемии). В
группу макроцитарных анемий входят
и мегалоцитарные (мегалобластические) анемии,
при которых СДЭ превышает 9,5 мкм (В12дефицитные анемии).
14.
Классификация анемий по типукроветворения
· с нормобластическим типом
кроветворения (нормальный эритропоэз:
эритробласт → пронормобласт → нормобласт
базофильный → нормобласт
полихроматофильный → нормобласт
оксифильный → эритроцит);
с мегалобластическим типом
кроветворения (промегалобласт →
мегалобласт базофильный → мегалобласт
полихроматофильный → мегалобласт
оксифильный → мегалоцит) (В12-дефицитные
анемии).
15.
Классификация анемий поспособности костного мозга к
регенерации
· регенераторные – с достаточной функцией
костного мозга (острая постгеморрагическая
и большинство гемолитических анемий),
· гипорегенераторные – понижение
регенераторной функции костного мозга
(железодефицитные, В12-дефицитные
анемии);
· арегенераторные (гипо - и апластические) –
с резким угнетением процессов эритропоэза.
Показателем достаточной регенераторной
способности костного мозга служит
развивающийся ретикулоцитоз.
16.
Железодефицитная анемия- гипохромная микроцитарная анемия,
развивающаяся вследствие абсолютного
уменьшения
запасов
железа
в
организме. Железодефицитная анемия
возникает, как правило, при хронической
потере крови или недостаточном
поступлении железа в организм.
17.
Этиология1. потери железа при хронических кровотечениях :
-- кровотечения из желудочно-кишечного тракта;
-- длительные и обильные менструации;
-- макро- и микрогематурия;
-- носовые, легочные кровотечения;
-- потери крови при гемодиализе;
-- неконтролируемое донорство;
2. недостаточное усваивание железа:
-- резекция тонкого кишечника;
-- хронический энтерит;
-- синдром мальабсорбции;
-- амилоидоз кишечника;
3. повышенная потребность в железе:
-- интенсивный рост;
-- беременность;
-- период кормления грудью;
-- занятия спортом;
4. недостаточное поступление железа с пищей:
-- новорожденные;
-- маленькие дети;
-- вегетарианство
18.
Клиническая картинаобщую слабость,
недомогание,
снижение работоспособности,
извращение вкуса, сухость и пощипывание языка, нарушение глотания с ощущением
инородного тела в горле, сердцебиение, одышка,
затруднение в сосредоточении внимания, иногда сонливость,
появляются головная боль, головокружение,
обмороки,
кожа обычно бледная, иногда с легким зеленоватым оттенком (хлороз) и с легко
возникающим румянцем щек, она становится сухой, дряблой, шелушится, легко
образуются трещины,
волосы теряют блеск, сереют, истончаются, легко ломаются, редеют и рано седеют,
ногти становятся тонкими, матовыми, уплощаются, легко расслаиваются и ломаются,
появляется исчерченность,
При выраженных изменениях ногти приобретают вогнутую, ложкообразную форму
(койлонихия),
у больных железодефицитной анемией возникает мышечная слабость,
атрофические изменения возникают в слизистых оболочках пищеварительного канала,
органов дыхания, половых органов. Поражение слизистой оболочки пищеварительного
канала - типичный признак железодефицитных состояний. Отмечается снижение
аппетита,
возникает потребность в кислой, острой, соленой пище. В более тяжелых случаях
наблюдаются извращения обоняния, вкуса (pica chlorotica): употребление в пищу мела,
известки, сырых круп, погофагия (влечение к употреблению льда).
19.
ЛечениеБольным железодефицитными анемиями рекомендуется
разнообразная диета, включающая мясные продукты
(телятина, печень) и продукты растительного
происхождения (бобы, сою, петрушку, горох, шпинат,
сушеные абрикосы, чернослив, гранаты, изюм, рис,
гречневую крупу, хлеб). Однако невозможно добиться
противоанемического эффекта только диетой. Если
даже больной будет питаться высококалорийными
продуктами, содержащими животный белок, соли
железа, витамины, микроэлементы,- можно достичь
всасывания железа не более 3-5 мг в сутки.
Необходимо применение препаратов железа. В
настоящее время в распоряжении врача имеется
большой арсенал лекарственных препаратов железа,
характеризующихся различным составом и свойствами,
количеством содержащегося в них железа, наличием
дополнительных компонентов, влияющих на
фармакокинетику препарата, различных лекарственных
форм.
20.
Причины В12 -дефицитной анемииАлиментарная недостаточность – недостаточное
поступление
с
пищей
(голодание,
строгое
вегетарианство (то есть отсутствие в питании не только
мяса, но также молочных продуктов и яиц), грудное
вскармливание матерью-вегетарианкой).
Нарушение всасывания витамина В12, поступившего с
пищей, в кровь.
Недостаточное количество внутреннего фактора Касла
(комплексное соединение, выделяемое клетками
слизистой оболочки желудка и соединяющееся с
витамином В12, поступившим в желудок с пищей.
Витамин В12 всасывается в тонком кишечнике только
в соединении с внутренним фактором Касла).
21.
Структурные изменения тонкого кишечника (хирургическоеудаление части тонкой кишки, повреждение внутренней
оболочки тонкой кишки различными микроорганизмами,
злокачественные новообразования
Поглощение витамина В12 микроорганизмами (бактериями
кишечника или глистами – внедрившимися в организм
человека круглыми или плоскими червями).
Неполноценное использование витамина В12 (нарушение
функций печени, и почек, и др.).
Повышенное потребление витамина В12 – любая
злокачественная опухоль (опухоль, растущая с
повреждением окружающих тканей), повышение выработки
гормонов (биологически активных веществ,
вырабатываемых железами организма) щитовидной железы,
грудной возраст.
Повышенное выделение витамина В12 – недостаточное
связывание с белками крови, заболевания печени и почек.
22.
Клиническая картинаАнемический:
◦
◦
◦
◦
◦
◦
слабость, снижение работоспособности;
головокружение;
обморочные состояния;
шум в ушах;
мелькание « мушек» перед глазами;
одышка (учащенное дыхание) и сердцебиение при незначительной
физической нагрузке;
◦ колющие боли в грудной клетке.
Гастроэнтерологический:
◦
◦
◦
◦
◦
снижение массы тела;
тошнота и рвота;
запоры;
снижение аппетита;
ощущение жжения в языке – проявление гюнтеровского глоссита
(изменения структуры языка вследствие дефицита витамина В12). Язык
становится ярко-красным или малиновым, « лакированным» (со
сглаженной поверхностью).
23.
Неврологический синдромОнемение и неприятные ощущения в конечностях.
◦ Скованность ног.
◦ Неустойчивость походки.
◦ Мышечная слабость.
◦ При длительном дефиците витамина В12 может
развиваться поражение спинного и головного мозга,
имеющее свои симптомы:
утрачивается вибрационная чувствительность (то есть
чувствительность к воздействиям колебаний на кожу) в
ногах;
появляются эпизоды резкого сокращения мышц (судороги).
Некоторые больные становятся
раздражительными, настроение снижается,
может нарушаться восприятие желтого и синего
цветов за счет повреждения головного мозга.
24.
Лечение В12-дефицитной анемииВоздействие на причину В12 -дефицитной анемии –
избавление от глистов (внедрившихся в организм плоских или
круглых червей), удаление опухоли, нормализация питания.
Восполнение дефицита витамина В12. Введение витамина
В12 внутримышечно в дозе 200-500 мкг в сутки. При
достижении стабильного улучшения следует вводить (в виде
внутримышечных инъекций) поддерживающие дозы – 100-200
мкг 1 раз в месяц в течение нескольких лет. При повреждении
нервной системы дозу витамина В12 повышают до 1000 мкг в
сутки на 3 дня, затем действует обычная схема.
Быстрое восполнение количества эритроцитов (красных
клеток крови) – переливание эритроцитарной массы
(эритроцитов, выделенных из донорской крови) по
жизненным показаниям (то есть при угрозе для жизни
пациента). Угрозой для жизни пациенту с В12-дефицитной
анемией являются два состояния:
◦ анемическая кома (утрата сознания с отсутствием реакции на
внешние раздражители вследствие недостаточного поступления
кислорода к головному мозгу в результате значительного или
быстро развившегося снижения количества эритроцитов);
◦ тяжелая степень анемии (уровень гемоглобина крови ниже 70 г/л,
то есть граммов гемоглобина на 1 л крови).
25.
Осложнения В12 -дефицитной анемииФуникулярный миелоз – поражение спинного мозга и
периферических нервов (то есть нервов, соединяющих
головной и спинной мозг со всеми органами),
проявляющееся
онемением
и
неприятными
ощущениями в конечностях, мышечной слабостью,
иногда – отсутствием чувствительности и движений в
ногах, недержанием мочи и кала.
Пернициозная (то есть злокачественная) кома – утрата
сознания с отсутствием реакции на внешние
раздражители вследствие недостаточного поступления
кислорода
к головному мозгу
в результате
значительного или быстро развившегося снижения
количества эритроцитов.
Ухудшение состояния внутренних органов, особенно при
наличии хронических заболеваний (например, сердца,
почек и др.).
26.
Профилактика В12-дефицитнойанемии
Употребление в пищу продуктов, богатых
витамином В12 (мясо, печень, яйца,
молочные продукты).
Своевременное лечение заболеваний,
приводящих к развитию дефицита
витамина В12 (например, глистных инвазий
– внедрения в организм человека глистов
(плоских и круглых червей)).
Назначение поддерживающей дозы
витамина В12 после операций,
сопровождающихся удалением части
желудка или кишечника.
27.
Гемобластозы(от греч. haima — кровь, blastos — зародыш, osis — болезнь) группа заболеваний кроветворной ткани, относящихся к
злокачественным новообразованиям.
Наиболее значимыми группами гемобластозов являются
лейкозы и лимфомы.
Лейкозы – системные опухолевые заболевания кроветворной
или лимфатической ткани, при которых опухолевый клон
исходит из клеток гемопоэтического ряда и первично
возникает в костном мозге.
Лейкозы затрагивают, главным образом, механизмы
миелопоэза или лимфопоэза, и часто (хотя и не при всех
формах и не в 100% случаев) характеризуются:
· лейкоцитозом;
· наличием незрелых и атипических клеток в периферической
крови;
· пролиферацией атипических клеток в костном мозге с
угнетением нормальной кроветворной ткани.
При лейкозах малигнизированные гемопоэтические клетки
первоначально пролиферируют в костном мозге, а затем
распространяются (по сути метастазируют) в периферическую
кровь, селезенку, лимфоузлы и другие ткани
28.
Классификация лейкозаЭто обусловлено тем, что острый лейкоз
возникает при трансформации незрелых
клеток (бластов). При этом начинается их
стремительное размножение и происходит
усиленный рост. Этот процесс невозможно
контролировать,
поэтому
вероятность
смертельного исхода при этой форме
заболевания достаточна высока.
Хронический
лейкоз развивается, когда
прогрессирует
рост
видоизмененных
полностью созревших кровяных клеток или
находящихся в стадии созревания. Он
отличается
длительностью
протекания.
Пациенту
достаточно
поддерживающей
терапии, чтобы его состояние оставалось
стабильным.
29.
Острые лейкозыГематологическая картина в развернутой стадии
заболевания характеризуется классической триадой:
· изменением содержания лейкоцитов (общее число
лейкоцитов снижено, повышено или остается нормальным);
· появлением в крови большого числа бластных клеток;
· «лейкемическим зиянием» (hiatus leukaemicus), когда в
периферической крови преобладают бластные клетки,
имеется небольшой процент зрелых лейкоцитов и
практически
отсутствуют
промежуточные
формы
созревания.
Уже
на
ранних
стадиях
болезни
отмечаются
нормохромная анемия и тромбоцитопения, развитие
которых обусловлено угнетением нормального гемопоэза
вследствие продукции лейкозным клоном цитокинов,
угнетающих пролиферацию нормальных стволовых клеток.
30.
Хронические лейкозы1.Хронический лимфолейкоз
2.Хронические миелопролиферативные
заболевания –
хронический миелоцитарный лейкоз (хр.
миелолейкоз) – ассоциирован с филадельфийской
хромосомой –
хронический моноцитарный лейкоз -истинная или
эссенцальная полицитемия
-эссенциальная тромбоцитемия
(мегакариоцитарный миелоз)
-сублейкемический миелоз (первичный
миелофиброз c миелоидной метаплазией,
миелоидная спленомегалия, остеомиелосклероз)
31.
Синдромы при лейкозахАнемический синдром. Связан с угнетением
эритроидного ростка костного мозга.
Геморрагический синдром (кровотечения из десен,
носа, кишечника; возможны кровоизлияния в жизненно
важные органы). Обусловлен снижением продукции
тромбоцитов.
Инфекционный синдром. Причиной его является
функциональная неполноценность лейкемических
лейкоцитов (снижение способности к фагоцитозу,
нарушение ферментного гомеостаза, угнетение синтеза
антител в лимфоцитах и т. д.)
Метастатический синдром. Проявляется нарушением
функций различных органов и систем вследствие
появления в них лейкемических инфильтратов.
Интоксикационный синдром. Связан с наводнением
организма нуклеопротеидами – токсическими
продуктами, образующимися при распаде (гибели)
лейкемических клеток.
32.
Общие симптомы лейкемииПри лейкозе большое значение имеет правильно поставленный диагноз и
своевременно начатое лечение. На начальной стадии симптомы лейкоза
крови любого вида больше напоминают простудные и некоторые другие
заболевания.
Человек испытывает слабость, недомогание. Ему постоянно хочется спать
или, наоборот, сон пропадает.
Нарушается мозговая деятельность: человек с трудом запоминает
происходящее вокруг и не может сосредоточиться на элементарных
вещах.
Кожные покровы бледнеют, под глазами появляются синяки.
Раны долго не заживают. Возможны кровотечения из носа и десен.
Без видимой причины повышается температура. Она может длительное
время держаться на уровне 37,6º.
Отмечаются незначительные боли в костях.
Постепенно происходит увеличение печени, селезенки и лимфатических
узлов.
Заболевание сопровождается усиленным потоотделением, сердцебиение
учащается. Возможны головокружения и обмороки.
Простудные заболевания возникают чаще и длятся дольше обычного,
обостряются хронические заболевания.
Пропадает желание есть, поэтому человек начинает резко худеть.
33.
Принципы лечения лейкозовЦитостатики (хлорбутин, циклофосфан)
– при развернутой стадии,
прогрессировании лимфаденопатии,
спленомеглии, лейкоцитоза
Глюкокортикоиды – при аутоиммунной
анемии, тромбоцитопении
Антибиотики, гамма-глобулин
Локальная лучевая терапия
Пересадка костного мозга
34.
Спасибо завнимание!


































 medicine
medicine